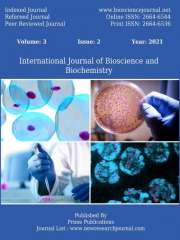
International Journal of Molecular Biology and Biochemistry Journal Subscription

Life Science and Biotechnology Journal Subscription
Showing 1–24 of 77 results for Life Science and Biotechnology
-

International journal of Pharmacy and biological sciences (IJPBS)
Original price was: ₹1,700.₹1,650Current price is: ₹1,650.17%
Off -

Britain International of Exact Sciences Journal (Indonesia)
Original price was: ₹3,500.₹3,150Current price is: ₹3,150.18%
Off -

European Scientific e-Journal
Original price was: ₹4,000.₹3,600Current price is: ₹3,600.18%
Off -

i-manager’s Journal on Life Sciences (JLS)
₹2,075 -

Indian Journal of Biotechnology and Pharmaceutical Research
₹3,5005%
Off -

Indian Journal of Health and Medical Law
₹3,500 -

International Journal of Advanced Geosciences
₹2,500 -

International Journal of Biochemistry and Biomolecule Research
₹3,500 -

International Journal of Bioinformatics and Computational Biology
₹3,500 -

International Journal of Biology Sciences
Original price was: ₹3,000.₹2,700Current price is: ₹2,700.18%
Off -

International Journal of Bionics and Bio-Materials
₹3,500 -

International Journal of Bioscience and Biochemistry
Original price was: ₹2,500.₹2,250Current price is: ₹2,250.18%
Off -

International Journal of Biotechnology and Microbiology
Original price was: ₹3,000.₹2,700Current price is: ₹2,700.18%
Off -

International Journal of Cell Biology and Cellular Functions
₹3,500 -

International Journal of Chemical and Molecular Engineering
₹3,500 -

International Journal of Emergency and Trauma Nursing and Practices
₹3,500 -

International Journal of Evidence-Based Nursing and Practices
₹3,500 -

International Journal of Genetic Modifications and Recombinations
₹3,500 -

International Journal of Industrial Biotechnology and Biomaterials
₹3,500 -

International Journal of Marine Life
₹3,500 -

International Journal of Membranes
₹3,500 -

International Journal of Midwifery Nursing and Practices
₹3,500 -
International Journal of Molecular Biology and Biochemistry
Original price was: ₹3,000.₹2,700Current price is: ₹2,700.10%
Off -

International Journal of Molecular Biotechnological Research
₹3,500











